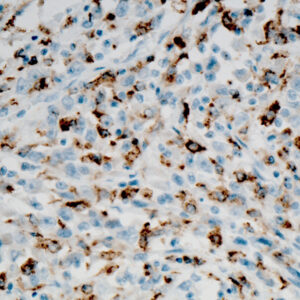
Anti-CD68

C
Showing 161–180 of 234 resultsSorted by latest
-
Anti-CD68
Price range: $350.00 through $1,060.00 Select options This product has multiple variants. The options may be chosen on the product page -

Anti-CD20
Price range: $300.00 through $1,180.00 Select options This product has multiple variants. The options may be chosen on the product page -

Anti-CD227 (MUCIN 1)
Price range: $250.00 through $965.00 Select options This product has multiple variants. The options may be chosen on the product page -

Anti-CD1a
Price range: $250.00 through $1,385.00 Select options This product has multiple variants. The options may be chosen on the product page -

Anti-Cathepsin D
Price range: $223.00 through $715.00 Select options This product has multiple variants. The options may be chosen on the product page -

Anti-CD10
Price range: $350.00 through $1,599.00 Select options This product has multiple variants. The options may be chosen on the product page -

Anti-CD105
Price range: $141.00 through $450.00 Select options This product has multiple variants. The options may be chosen on the product page -

Anti-CD22
Price range: $130.00 through $1,132.00 Select options This product has multiple variants. The options may be chosen on the product page -

Anti-CD2
Price range: $250.00 through $1,239.00 Select options This product has multiple variants. The options may be chosen on the product page -

Anti-CD16
Price range: $250.00 through $995.00 Select options This product has multiple variants. The options may be chosen on the product page -

Anti-CD35
Price range: $250.00 through $1,299.00 Select options This product has multiple variants. The options may be chosen on the product page -

Anti-CD5
Price range: $250.00 through $1,705.00 Select options This product has multiple variants. The options may be chosen on the product page -

Anti-CA 125
Price range: $325.00 through $1,189.00 Select options This product has multiple variants. The options may be chosen on the product page -

Anti-CA 19-9
Price range: $325.00 through $1,495.00 Select options This product has multiple variants. The options may be chosen on the product page -

Anti-CD117
Price range: $350.00 through $1,449.00 Select options This product has multiple variants. The options may be chosen on the product page -

Anti-CD4
Price range: $325.00 through $1,789.00 Select options This product has multiple variants. The options may be chosen on the product page -

Anti-CD68
Price range: $250.00 through $1,289.00 Select options This product has multiple variants. The options may be chosen on the product page -

Anti-CD79a
Price range: $250.00 through $1,359.00 Select options This product has multiple variants. The options may be chosen on the product page -

Anti-CDX-2
Price range: $250.00 through $2,595.00 Select options This product has multiple variants. The options may be chosen on the product page -

Anti-Collagen IV
Price range: $250.00 through $1,195.00 Select options This product has multiple variants. The options may be chosen on the product page
